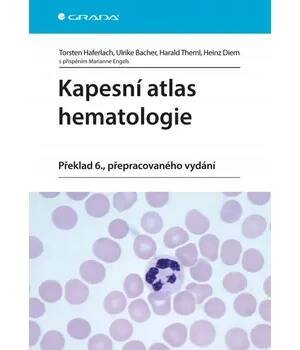

- Všechny velikosti
- Velké
- Malé
- Barevné
- Černobílé
- Jen barevné

Kardiopatologie562 Kč
megaknihy.czSkladem

digiport.czSkladem

Biologická léčiva - Martin Fusekod 280 Kč
zbozi.czSkladem

Klinická propedeutika297 Kč
digiport.czSkladem

restorio.czNení skladem

Klinická farmacie I543 Kč
alza.czSkladem

Klinická farmacie II382 Kč
alza.czSkladem

zbozi.czSkladem

Obálka knihy764 Kč
kosmas.czSkladem

ikiosek.czSkladem
odkazuje na služby nejen od Seznam.cz.
© 1996–2025 Seznam.cz, a.s.



![Nádory podjaterní oblasti [Kniha] - Zdeněk Kala](https://img.obrazky.cz/?url=77b3226a19181131&size=2)